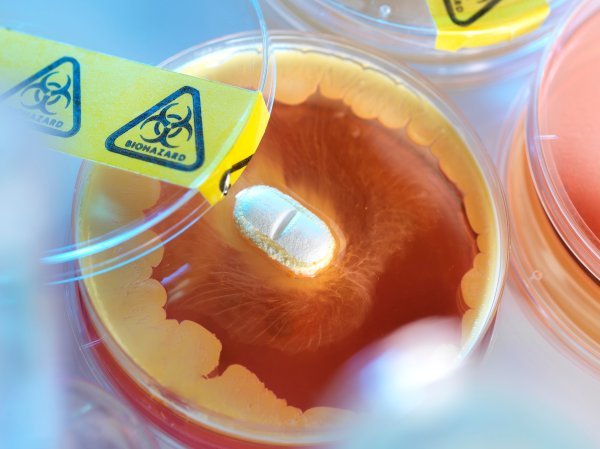
Lijekovi
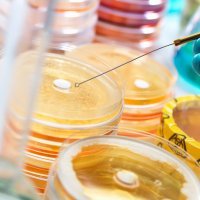
Lijekovi

Sukob između Kine i Tajvana imao bi katastrofalan učinak na kinesku opskrbu Europe vitalnim lijekovima, upozorava europska farmaceutska industrija
'Kriza u Tajvanu mogla bi izazvati potpunu nestašicu nekih lijekova. Bila bi to dramatična situacija', rekla je Roberta Pizzocaro, predsjednica Olona, milanske tvrtke koja proizvodi oko 300 farmaceutskih sastojaka koji ulaze u gotove lijekove.
Posljednjih godina rastu tenzije oko statusa Tajvana. Otočna država ima samoupravu, ali Kina je smatra dijelom svog teritorija i provodi velike vojne vježbe na tom području, dok SAD obećava da će je braniti u slučaju invazije.
'Ako Kina napadne Tajvan, a mi to sankcioniramo, kao što smo učinili Rusiji, farmaceutsko tržište okrenulo bi se naglavačke. Nemamo mnogo alternativa', izjavio je Gian Paolo Negrisoli, izvršni direktor farmaceutskog proizvođača Flamma Group.
Kina je postala farmaceutska sila u posljednjih 20 godina jer su joj blaži ekološki propisi, jeftina radna snaga i općenito niži troškovi omogućili da dominira proizvodnjom.
Kinezi su veliki proizvođač nebrendiranih starijih lijekova koji se rutinski koriste u bolnicama. Naprimjer, proizvodnja antibiotika sve se više seli u Aziju, a Kina dominira tim segmentom.
Peking trenutno kontrolira otprilike 90 posto globalne opskrbe inputima potrebnima za proizvodnju generičkih antibiotika koji liječe bronhitis, upalu pluća, pedijatrijske infekcije uha i stanja opasna po život kao što je sepsa. Kina je i ključni izvoznik lijekova za krvni tlak i lijekova protiv bolova. Također opskrbljuje europsku farmaceutsku industriju osnovnim sastojcima koji se koriste u proizvodnji.
Europa trenutno proizvodi samo četvrtinu svjetskih aktivnih farmaceutskih sastojaka te se sve više oslanja na uvoz. Kina i Indija, u međuvremenu, proizvode više od polovice, s tim da se i Indija oslanja na Kinu.
Studija koju je provela tvrtka za istraživanje tržišta IQVIA za European Fine Chemicals Group procjenjuje da Europa ovisi o Aziji za tri četvrtine svojih farmaceutskih sastojaka i prekursora kemikalija - s tim da na Kinu otpada 70 posto.
Tvrtke kao što su Olon i Flamma Group sada rade na diversifikaciji svojih opskrbnih lanaca, ali to nije uvijek moguće. Mnogi farmaceutski sastojci proizvode se samo u Aziji, a neki isključivo u Kini, rekao je Pizzocaro.
U drugim sektorima, kao što su sirovine ili mikročipovi, Europa je počela jačati svoje proizvodne kapacitete. Zasad farmaceutska industrija debelo zaostaje u tome.
Međutim prošlog mjeseca Belgija je predložila donošenje zakona o kritičnim lijekovima, po uzoru na europski Zakon o mikročipovima. Ukupno 21 zemlja podržala je tu ideju i sada je na Europskoj komisiji da iznese konkretan prijedlog.